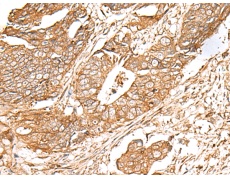
一抗

|
Background: |
This gene encodes a product belonging to a family of proteins with unknown function. The presence of two transmembrane domains suggests that this protein is a multi-pass membrane protein. |
|
Applications: |
ELISA, WB, IHC |
|
Name of antibody: |
FAM155B |
|
Immunogen: |
Synthetic peptide of human FAM155B |
|
Full name: |
family with sequence similarity 155 member B |
|
Synonyms: |
TED; TMEM28; CXorf63; bB57D9.1 |
|
SwissProt: |
O75949 |
|
ELISA Recommended dilution: |
5000-10000 |
|
IHC positive control: |
Human cervical cancer and Human colorectal cancer |
|
IHC Recommend dilution: |
40-200 |
|
WB Predicted band size: |
53 kDa |
|
WB Positive control: |
Human heart tissue lysate |
|
WB Recommended dilution: |
200-1000 |



 購物車
購物車 幫助
幫助
 021-54845833/15800441009
021-54845833/15800441009